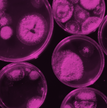
Branding used for Access Microbiology
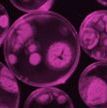
access-microbiology.jpg

Press releases
- Order by:
- Date
- A-Z
-
First extensive study into marsupial gut microbiomes reveals new microbial species and antimicrobial resistance
13 January 2026
The first study detailing the species within the gut microbiomes of many of Australia's iconic marsupial species is published in Microbial Genomics. The paper, titled 'A molecular inventory of the faecal microbiomes of 23 marsupial species, deepens understandings of the microbes and the impacts of environment on host microbiomes, such as animal location, diet and captivity.
- Order by:
- Date
- A-Z
-
Persistent antibiotic resistance of cholera-causing bacteria in Africa revealed from a multinational workshop for strengthening disease surveillance
10 December 2025
A new study, 'Genomic diversity and antimicrobial resistance of Vibrio cholerae isolates from Africa: a PulseNet Africa initiative using nanopore sequencing to enhance genomic surveillance', published in Microbial Genomics today outlines the findings from a collaborative workshop to strengthen local capabilities for disease surveillance.
-
Researchers discover new viruses in Antarctic penguins, expanding viral knowledge in polar ecosystems
24 November 2025
International research team identify 35 viral genomes in Antarctic penguins, revealing how wildlife and viruses evolve together in extreme environments. The paper, titled 'Diversity of polyomaviruses and papillomaviruses in penguins from eastern and western Antarctica' is published in Microbial Genomics.
-
Surprising bacteria discovery links Hawaiʻi’s groundwater to the ocean
17 October 2025
Researchers at the University of Hawaii Mānoa, alongside undergraduate students, describe a new species of bacteria isolated from seawater off the coast of O'ahu in a new paper 'Caulobacter inopinatus sp. nov., from seawater off O‘ahu, Hawai‘i, and emended description of the genus Caulobacter,' published in the International Journal of Systematic and Evolutionary Microbiology.
-
Koala stress linked to disease threat
22 September 2025
Researchers from the University of Queensland reveal the relationship between levels of stress hormones and increased susceptibility to secondary infection in koalas with koala retrovirus (KoRV), an often fatal disease contributing towards their declining populations, in a new paper 'Temporal dynamics of koala retrovirus plasma RNA load in relation to faecal glucocorticoid metabolites and Chlamydia infection,' published in the Journal of General Virology.
-
First systematic review finds gut-brain axis impacts treatment outcomes in bipolar patients
18 June 2025
- The first systematic review on the effects of bipolar medications on the gut microbiome furthers our understanding of the connection between the gut and the brain in patients treated for bipolar disorder.
- By analysing existing datasets, researchers concluded that the health of the gut microbiome may predict a patient’s response to treatment with drugs.
- The results of the study could pave the way for new personalised therapeutic strategies and inspire further studies and clinical trials focused on treatments with the microbiome in mind.
- Order by:
- Date
- A-Z
-
Sciety welcomes Access Microbiology for the public review and curation of microbiology research
12 December 2024
Sciety is pleased to welcome the open research platform Access Microbiology to its community, bringing public evaluation to the latest microbiology and virology research.
-
Fee-free Open Access publishing in Microbiology Society titles for developing and transition economy countries and territories: new agreement signed with EIFL
11 December 2024
As part of its ongoing efforts to make Open Access (OA) publishing more equitable, the Microbiology Society is pleased to announce a new Article Processing Charge (APC) waiver agreement with Electronic Information for Libraries (EIFL). The agreement, commencing in January 2025, will cover unlimited fee-free OA publishing in all Society titles for researchers across 33 developing and transition economy countries and territories.
-
How did human brains get so big? The answer could be in our gut.
03 December 2024
Microbes supporting the production of more metabolic energy could be key to the evolution of large brains.
- New research provides the first evidence that differences in gut microbiomes across species are linked to how energy is used in the body. This could have shaped human evolution of larger brains.
- The gut microbiome is a community of microorganisms in the digestive system. Previous research has linked changes in the gut microbiome to changes in host metabolism (the processes in the body that convert or use energy).
- The study found that mice given gut microbes taken from large-brained primates ate more and shifted their energy usage to glucose – the brain’s primary fuel source. Whereas the mice that were given gut microbes from smaller-brained primates stored the energy as fat.
- This change in energy utilization could be an explanation of how humans were able to evolve large brains relative to body size that are energetically expensive to maintain.
-
A Lung on a Chip: a new tool to combat coronavirus
11 September 2024
Researchers from the Quadram Institute working together with the UK Health Security Agency (UKHSA) have established a human “lung-on-chip” model that recreates how SARS-CoV-2 infects lung cells, in a contained laboratory environment.
-
New Microbiology Society Publish and Read consortium deal now available to science institutions and hospitals across Germany
28 August 2024
The Microbiology Society, one of the largest microbiology societies in Europe, is pleased to announce a new three-year Publish and Read offering with German consortium ZB MED – Information Centre for Life Sciences, available to its 400 member institutions and 2,000 hospitals. This agreement was established in partnership with HARRASSOWITZ, the Society’s representative agency in Germany.
- Order by:
- Date
- A-Z
-
The Microbiology Society launches on WeChat to better connect with Chinese researchers
05 December 2023
The Microbiology Society is pleased to announce that it has launched its official account on WeChat, China’s preeminent social media platform, in partnership with Charlesworth. With a goal to better connect with China-based researchers and improve accessibility to its six peer-reviewed titles, this is a significant step in extending reach to international authors.
-
Chlorine disinfectant is no more effective than water at killing off hospital superbug, study shows
22 November 2023
Research published during World Antimicrobial Awareness Week explores the impact of using recommended chlorine chemicals to tackle Clostridioides difficile, the most common cause of antibiotic associated sickness in healthcare settings globally
-
UJ researchers discover new bacterial species with healthcare potential in South African medicinal plant
14 November 2023
Researchers from the University of Johannesburg have discovered a new bacteria species living inside an African medicinal plant, which may be found to have healthcare applications in future.
-
Tracking the bacteria behind life-threatening sepsis in premature babies
04 October 2023
A new study from the Quadram Institute and University of East Anglia into sepsis in neonatal babies has uncovered the secrets of the bacteria’s success in causing this life-threatening condition.
Using genomic sequencing, they have found how certain strains of bacteria that usually live harmlessly on the skin can evade control measures by colonising babies’ guts. This will provide new ways to control this threat to babies’ health.
-
Whole Genome Sequencing can transform the management of Healthcare-Associated Infections
23 August 2023
An economic model by bioinformatics company Genpax published in Microbial Genomics concludes that in England the National Health Service (NHS) could save close to £0.5bn and prevent 1200 avoidable deaths, and the US health system over $3bn and 4,800 deaths by implementing whole genome sequencing (WGS) as a tool to control bacterial healthcare-associated infections.
- Order by:
- Date
- A-Z
-
Take probiotics alongside your prescribed antibiotics to reduce damage to your gut microbiome, says the first review of the data
16 November 2022
The first ever systematic review of its kind confirms that taking probiotics alongside antibiotics can protect against some of the negative impacts of antibiotics on the human gut microbiome. The review is reported in the Journal of Medical Microbiology, published by the Microbiology Society.
-
Microbiologists react: Health Secretary comments on access to antibiotics
17 October 2022
Antimicrobial resistance (AMR) is an insidious and silent pandemic that is already happening, when bacteria are exposed to levels of antibiotics that do not kill them, they develop ways to overcome further treatments. The latest figures reveal that an estimated 1.2 million people died in 2019 as a direct result of antibiotic-resistant bacterial infections and that AMR will cause over 10 million deaths per year by 2050, which is more than deaths from cancer and diabetes combined, and more than the current COVID-19 death toll.
-
Naming unnamed species of bacteria in the age of big data
20 September 2022
In a recently published paper, researchers in the UK and Austria have named over 65,000 different kinds of microbes. The study, led by Professor Mark Pallen at the Quadram Institute in Norwich, UK, draws on a long tradition of creating well-formed but arbitrary Latin names for new species, but applies this approach at a scale unprecedented in the history of taxonomy.
-
Health leader honoured by bacteria naming
13 September 2022
Scientists often name new discoveries after celebrities – such as the Beyoncé horse fly (Scaptia beyoncea), the Steve Irwin snail (Crikey steveirwini) or the David Bowie huntsman spider (Heteropoda davidbowie).
So when University of Adelaide researchers discovered a new type of lactic acid bacteria, they wanted to pay homage to someone who allowed them to continue their work during the height of the COVID-19 pandemic.
-
Manuka honey could help to clear deadly drug-resistant lung infection
08 September 2022
Scientists develop a potential nebulisation treatment using manuka honey to clear a drug resistant lung infection that can be fatal in cystic fibrosis patients. Aston University researchers combined the antibiotic amikacin with manuka honey as a novel treatment for Mycobacterium abscessus. Using the manuka honey combination resulted in an eight-fold reduction in the dosage of the antibiotic.
- Order by:
- Date
- A-Z
-
Transformative agreement signed between the Microbiology Society and the Max Planck Digital Library
01 December 2021
The Microbiology Society and the Max Planck Digital Library (MPDL) are pleased to announce a three-year transformative agreement starting in 2022. The Publish and Read model will enable researchers of 86 Max Planck Institutes in Germany to publish any article accepted for publication in the journals of the Society Open Access, without having to pay Article Processing Charges (APCs).
-
Increasing transparency and openness
18 June 2021
The Microbiology Society is pleased to announce three new initiatives that provide article-level metrics of all Open Access (OA) articles published by the Society’s six journals.
-
‘Overly-stringent’ criteria early in the pandemic led to missed diagnoses of COVID-19
16 June 2021
Research published today in the Journal of General Virology has identified missed cases of SARS-CoV-2 by retrospective testing of throat swabs.
Researchers at the University of Nottingham screened 1,660 routine diagnostic specimens which had been collected at a Nottingham hospital between 2 January and 11 March 2020 and tested for SARS-CoV-2 by PCR. At this stage of the pandemic, there was very little COVID-19 testing available in hospitals, and to qualify patients had to meet a strict criterion, including recent travel to certain countries in Asia or contact with a known positive case. -
The new species of bacteria killing palms in Australia
28 May 2021
While investigating a disease outbreak in a Queensland botanical gardens, researchers discovered a new species of bacteria that causes a fatal disease in palms.
The bacterium, which they named Candidatus Phytoplasma dypsidis was found to cause a fatal wilt disease. This new discovery was reported in the International Journal of Systematic and Evolutionary Microbiology. -
One year of SARS-CoV-2 evolution
15 April 2021
Today, researchers published an in-depth look at the SARS-CoV-2 mutations that have taken place during the past year in the Journal of General Virology. The review discusses the findings of over 180 research articles and follows the changes that have taken place in the SARS-CoV-2 genome, and the variants that have occurred as a result.
- Order by:
- Date
- A-Z
-
Does science have a plastic problem? – Microbiologists take steps to reducing plastic waste
15 October 2020
“Everyone can make a difference!” urge microbiologists after developing a new approach that could reduce their laboratory’s plastic waste by over 500kg a year.
The group, based at the University of Edinburgh’s Roslin Institute, developed an approach to reduce plastic waste produced by their lab. They have shared their approach in the journal Access Microbiology, with the hope that other labs will follow suit. -
A new, 20-minute assay for COVID-19 diagnosis
13 August 2020
Researchers have developed a new test that can diagnose COVID-19 in just 20 minutes.
The findings, published in the Journal of Medical Microbiology, show the rapid molecular test called N1-STOP-LAMP, is 100% accurate in diagnosing samples containing SARS-CoV-2 at high loads.
-
Turmeric could have antiviral properties
17 July 2020
Curcumin, a natural compound found in the spice turmeric, could help eliminate certain viruses, research has found.
A study published in the Journal of General Virology showed that curcumin can prevent Transmissible gastroenteritis virus (TGEV) – an alpha-group coronavirus that infects pigs – from infecting cells. At higher doses, the compound was also found to kill virus particles.
-
Repurposing public health systems to decode COVID-19
07 July 2020
Existing public health monitoring systems in the UK, could improve understanding of the risk factors associated with severe COVID-19.
-
Immunity to coronaviruses: what do we know so far?
21 May 2020
A new review discusses the findings from over 40 studies on coronavirus immunity and what they could mean for the COVID-19 pandemic.
- Order by:
- Date
- A-Z
-
Bacterial hitchhikers on the International Space Station
10 October 2019
Bacteria have been found in the International Space Station’s drinking water. A research article published in the journal Microbiology discussed the bacteria found coating drinking water pipes and tanks on the International Space Station (ISS).
-
Unexpected microbiome collapse after admission to intensive care
01 October 2019
Potentially harmful microbes overwhelm the healthy gut microbiota in intensive care patients, research has found. Research published in the journal Microbial Genomics assessed how the diversity and makeup of the gut microbiome varied during patients’ time in the intensive care unit (ICU). The gut microbiome is the complex community of bacteria and other microbes that reside in the gut, and plays an important role in health and wellbeing.
-
The microbes in your gut could be used to predict whether you are likely to develop cancer
10 September 2019
The makeup of the bacterial community that lives in the gut has been identified as a risk factor for bowel cancer. Research has found that the composition of the intestinal microbiome – the complex community of bacteria and other microbes that reside in the gut – can influence an individual’s chances of developing cancer in the bowel.
-
Could dogs be the source of a new flu?
28 March 2019
Results from a 10-year study suggest two strains of influenza that could mix and form a dangerous new strain of influenza spread by dogs.
-
Harnessing soil microbes to enhance crop performance
28 March 2019
A recently-isolated soil microbe could be used to modify crops and protect them against fungal diseases, researchers say. Researchers at the Agriculture and Food Development Authority (TEAGASC) have identified a novel bacterium which can modify plant characteristics and provide beneficial traits, such as resistance to diseases.
- Order by:
- Date
- A-Z
-
Using microbiology to bring single use plastics into a circular economy
30 November 2018
Useful products could be generated from biodegrading plastics, researchers say. In a review published in the journal Microbiology, Tanja Narancic and Kevin O’Connor discuss the advances made in biodegradation of fossil-based plastics, the design of plastics for biodegradation and how microbes can transform plastic waste into useful products.
-
New bacteria discovered in Cornwall
12 September 2018
A new species of bacteria has been discovered on a man in Cornwall. The bacteria was found on a 64 year old man seeking treatment for cellulitis. When researchers attempted to find the cause of this skin infection, they found the bacteria, which although similar to others, had not been seen before
-
Cinnamon essential oil could make bacterial infections easier to treat
12 July 2018
Researchers have found that a major component of cinnamon oil can help to clear certain bacterial infections.
-
Ebola in Democratic Republic of Congo ‘has the potential for rapid expansion'
31 May 2018
An expert has compared the ongoing Ebola outbreak in the Democratic Republic of Congo to the 2014 west African epidemic that killed more than 11,000 people.
- Order by:
- Date
- A-Z
-
An unbalanced microbiome on the face may be key to acne development
06 April 2017
Today at the Microbiology Society’s Annual Conference, researchers will show that the overall balance of the bacteria on a person’s skin, rather than the presence or absence of a particular bacterial strain, appears to be an important factor for acne development and skin health.
-
HPV immunisation campaign causes massive reduction in prevalence of cancer-causing virus in Scottish women
05 April 2017
Today, at the Microbiology Society’s Annual Conference in Edinburgh, researchers will show that levels of cancer-causing human papillomavirus in Scotland have dropped 90% in young women, following a vaccination campaign that began in 2008. The researchers believe that this may itself lead to a 90% reduction in cervical cancer cases in Scottish women.
- Order by:
- Date
- A-Z
-
Using frog foam to deliver antibiotics
23 March 2016
Today, at the Microbiology Society’s Annual Conference in Liverpool, scientists will show that the foam made by Trinidadian frogs represents a new, non-toxic antibiotic delivery system that may help to prevent infections.
-
Unaccounted for Arctic microbes appear to be speeding up glacier melting
18 March 2016
Today, at the Microbiology Society’s Annual Conference in Liverpool, scientists will reveal how Arctic microbes are increasing the rate at which glaciers melt, in a process not accounted for in current climate change models.
-
Parliamentary Committee report exposes weaknesses in UK response to Ebola
25 January 2016
Today, the UK House of Commons Science and Technology Select Committee published the report from their inquiry entitled Science in Emergencies: UK Lessons from Ebola, which makes wide-ranging recommendations to the Government to improve the UK’s preparedness for, and response during, future infectious disease outbreaks.
- Order by:
- Date
- A-Z
-
Researchers discover bacterial genetic pathway involved in body odour production
31 March 2015
For many, body odour is an unfortunate side effect of their daily lives. The smell is caused by bacteria on the skin breaking down naturally secreted molecules contained within sweat. Now, researchers from the University of York working with Unilever have studied the underarm microbiome and identified a unique set of enzymes in the bacterium Staphylococcus hominis that is effective at breaking down sweat molecules into compounds known as thioalcohols, an important component of the characteristic body odour smell.
-
Date syrup shows promise for fighting bacterial infections
31 March 2015
Date syrup – a thick, sweet liquid derived from dates that is widely consumed across the Middle East – shows antibacterial activity against a number of disease-causing bacteria, including Staphylococcus aureus and Escherichia coli.
New research, presented today at the Society for General Microbiology Annual Conference in Birmingham, showed that, in vitro, date syrup is able to inhibit the growth of bacteria faster than manuka honey, which has previously been shown to have antibacterial properties and is increasingly used in dressings to improve wound repair.
-
Researchers from Nottingham rediscover Anglo-Saxon antimicrobial
31 March 2015
Researchers from the University of Nottingham have shown that a 1,000 year old Anglo-Saxon remedy for eye infections, which originates from a manuscript in the British Library, has been found to kill the modern-day superbug MRSA. This work is being presented this week at the Society for General Microbiology Annual Conference.
Microbiologist Dr Freya Harrison, working with Dr Steve Diggle and Dr Aled Roberts, collaborated with Dr Christina Lee, an Anglo-Saxon expert from the School of English, to recreate a 10th century potion for eye infections from Bald’s Leechbook. The book is widely thought of as one of the earliest known medical textbooks and contains Anglo-Saxon medical advice and recipes for medicines, salves and treatments.
-
Antibiotic resistance risk for coastal water users
30 March 2015
Recreational users of coastal waters such as swimmers and surfers are at risk of exposure to antibiotic resistant bacteria, according to new research published this week and presented today at the Annual Conference.
- Order by:
- Date
- A-Z
-
New research shows bacteria survive longer in contact lens cleaning solution than previously thought
17 April 2014
Each year in the UK, bacterial infections cause around 6,000 cases of a severe eye condition known as microbial keratitis – an inflammation and ulceration of the cornea that can lead to loss of vision. The use of contact lenses has been identified as a particular risk factor for microbial keratitis.
-
New research shows how pathogenic E. coli O157:H7 binds to fresh vegetables
16 April 2014
Food poisoning outbreaks linked to disease-causing strains of the bacterium Escherichia coli are normally associated with tainted meat products. However, between 20-30% of these are caused by people eating contaminated vegetables, as was seen in the 2011 outbreak in Europe that caused 53 deaths. Research presented today at the Society for General Microbiology’s Annual Conference shows that the disease-causing E. coli O157:H7 interacts directly with plant cells, allowing it to anchor to the surface of a plant, where it can multiply.
-
Awareness campaign shows signs of delaying onset of drug resistant gonorrhoea in UK
15 April 2014
Control of gonorrhoea is dependent on successful antibiotic treatment, and the bacterium that causes the infection, Neisseria gonorrhoeae, has become increasingly resistance to every antibiotic used to treat it over the last 60 years. Today, at the Society for General Microbiology’s Annual Conference in Liverpool, Professor Cathy Ison explains the challenges facing the treatment of the disease, which threatens to become resistant to all antibiotics.
-
Reduction in HPV in young women in England seen following introduction of national immunisation programme
14 April 2014
Infection with high-risk human papillomavirus (HR HPV) types 16 and 18 is responsible for around 70-80% of cervical cancers. A study conducted by Public Health England and presented today at the Society for General Microbiology's Annual Conference shows a reduction in these two HR HPV types – which are included in the HPV vaccines used – in sexually active young women in England.
- Order by:
- Date
- A-Z
-
Research identifies how mouth cells resist Candida infection
03 September 2013
Candida albicans is a common fungus found living in, and on, many parts of the human body. Usually this species causes no harm to humans unless it can breach the body’s immune defences, where can lead to serious illness or death. It is known as an opportunistic pathogen that can colonise and infect individuals with a compromised immune system. New research, presented today at the Society for General Microbiology’s Autumn Conference, gives us a greater understanding of how mucosal surfaces in the body respond to C. albicans to prevent damage being done during infection.
-
Stomach bacteria switch off human immune defences to cause disease
02 September 2013
Helicobacter pylori is a bacterium that establishes a life-long stomach infection in humans, which in some cases can lead to duodenal ulcers or stomach cancer. New research, presented today at the Society for General Microbiology’s Autumn Conference, gives us a clearer understanding of how these bacteria can manipulate the human immune system to survive in the mucosal lining of the stomach.
- Order by:
- Date
- A-Z
-
Coconut oil could combat tooth decay
03 September 2012
Digested coconut oil is able to attack the bacteria that cause tooth decay. It is a natural antibiotic that could be incorporated into commercial dental care products, say scientists presenting their work at the Society for General Microbiology’s Autumn Conference at the University of Warwick.
-
Bacterial cause found for skin condition rosacea
30 August 2012
Rosacea is a common dermatological condition that causes reddening and inflammation of the skin mostly around the cheeks, nose and chin. In severe cases skin lesions may form and lead to disfigurement. Rosacea affects around 3% of the population – usually fair-skinned females aged 30-50 and particularly those with weak immune systems. The condition is treated with a variety of antibiotics, even though there has never been a well-established bacterial cause.
-
Honey could be effective at treating and preventing wound infections
31 January 2012
Manuka honey could help clear chronic wound infections and even prevent them from developing in the first place, according to a new study published in Microbiology. The findings provide further evidence for the clinical use of manuka honey to treat bacterial infections in the face of growing antibiotic resistance.